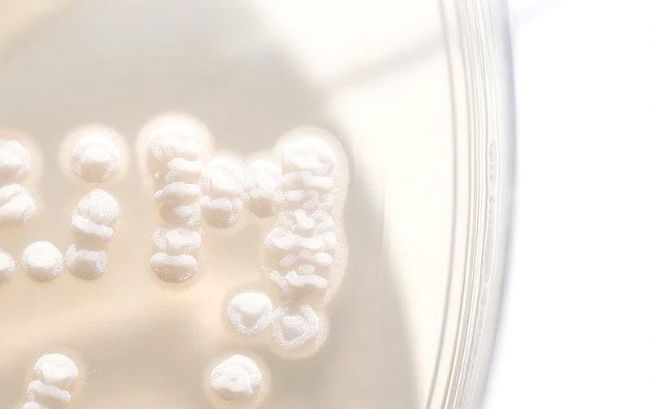

空間滅菌在農(nóng)業(yè)生產(chǎn)中的應(yīng)用
在農(nóng)業(yè)微生物菌劑的生產(chǎn)過(guò)程中,有一種“隱形殺手”常常讓技術(shù)員夜不能寐——噬菌體污染。
它能在不經(jīng)意間侵入接種臺(tái)、培養(yǎng)區(qū)、發(fā)酵系統(tǒng),造成菌種大規(guī)模崩潰,甚至整批產(chǎn)品報(bào)廢;與此同時(shí),空氣中漂浮的雜菌也在悄無(wú)聲息中干擾你的無(wú)菌操作流程,成為影響產(chǎn)率與質(zhì)量的“幕后黑手”。
在努力做科研、拼生產(chǎn)的同時(shí),你是否也遇到過(guò)這些困擾?


痛點(diǎn)一:空氣雜菌超標(biāo),干擾發(fā)酵與菌種穩(wěn)定性
即使嚴(yán)格執(zhí)行無(wú)菌操作、設(shè)有潔凈區(qū),仍無(wú)法完全隔絕空氣中的雜菌污染:


痛點(diǎn)二:菌種退化頻發(fā),背后竟是“亞臨界污染”
在連續(xù)批次生產(chǎn)中,你是否發(fā)現(xiàn)菌株活性、代謝效率逐漸降低?
這是典型的低劑量空氣污染誘發(fā)菌株應(yīng)激的表現(xiàn):

痛點(diǎn)三:多點(diǎn)交叉作業(yè),污染“偷偷擴(kuò)散”
微生物工廠常在同一空間內(nèi)開(kāi)展多環(huán)節(jié)操作:
接種→ 擴(kuò)培 → 發(fā)酵 → 濃縮 → 包裝
操作人員流動(dòng)頻繁,物料、容器、設(shè)備傳遞頻繁,如果空氣不潔凈,就會(huì)形成一條看不見(jiàn)的“污染傳播鏈”。
✅ AEM-300空間滅菌器 —— 你真正需要的“空氣防線”
為解決微生物實(shí)驗(yàn)與菌劑生產(chǎn)中的“空氣污染死角”,觀微生物研發(fā)團(tuán)隊(duì)推出了AEM-300 空間滅菌器,專為農(nóng)業(yè)微生物應(yīng)用場(chǎng)景設(shè)計(jì)。
三大核心技術(shù):
它能在不經(jīng)意間侵入接種臺(tái)、培養(yǎng)區(qū)、發(fā)酵系統(tǒng),造成菌種大規(guī)模崩潰,甚至整批產(chǎn)品報(bào)廢;與此同時(shí),空氣中漂浮的雜菌也在悄無(wú)聲息中干擾你的無(wú)菌操作流程,成為影響產(chǎn)率與質(zhì)量的“幕后黑手”。
在努力做科研、拼生產(chǎn)的同時(shí),你是否也遇到過(guò)這些困擾?

痛點(diǎn)一:空氣雜菌超標(biāo),干擾發(fā)酵與菌種穩(wěn)定性
即使嚴(yán)格執(zhí)行無(wú)菌操作、設(shè)有潔凈區(qū),仍無(wú)法完全隔絕空氣中的雜菌污染:
- 空調(diào)換風(fēng)系統(tǒng)不穩(wěn)定,空氣循環(huán)帶來(lái)二次污染;
- 培養(yǎng)間/接種間殘留真菌孢子、芽孢桿菌等雜菌,競(jìng)爭(zhēng)營(yíng)養(yǎng);
- 灰塵與氣溶膠中夾帶的噬菌體顆粒,輕松突破防線侵入培養(yǎng)體系。

痛點(diǎn)二:菌種退化頻發(fā),背后竟是“亞臨界污染”
在連續(xù)批次生產(chǎn)中,你是否發(fā)現(xiàn)菌株活性、代謝效率逐漸降低?
這是典型的低劑量空氣污染誘發(fā)菌株應(yīng)激的表現(xiàn):
- 微量雜菌干擾長(zhǎng)期積累,誘導(dǎo)菌株產(chǎn)生“抗壓”變異;
- 噬菌體反復(fù)低水平存在,引發(fā)菌株自我調(diào)控紊亂;
- 最終表現(xiàn)為:菌落性狀變化、發(fā)酵產(chǎn)物減少、制劑效果下降。
痛點(diǎn)三:多點(diǎn)交叉作業(yè),污染“偷偷擴(kuò)散”
微生物工廠常在同一空間內(nèi)開(kāi)展多環(huán)節(jié)操作:
接種→ 擴(kuò)培 → 發(fā)酵 → 濃縮 → 包裝
操作人員流動(dòng)頻繁,物料、容器、設(shè)備傳遞頻繁,如果空氣不潔凈,就會(huì)形成一條看不見(jiàn)的“污染傳播鏈”。
- 一個(gè)污染點(diǎn),影響五個(gè)環(huán)節(jié);
- 一次輕忽,污染整條產(chǎn)線。
✅ AEM-300空間滅菌器 —— 你真正需要的“空氣防線”
為解決微生物實(shí)驗(yàn)與菌劑生產(chǎn)中的“空氣污染死角”,觀微生物研發(fā)團(tuán)隊(duì)推出了AEM-300 空間滅菌器,專為農(nóng)業(yè)微生物應(yīng)用場(chǎng)景設(shè)計(jì)。
三大核心技術(shù):
- 等離子體滅菌:強(qiáng)氧化清除空氣中生物顆粒;
- 雙波段UVC消殺:高強(qiáng)度紫外對(duì)噬菌體殺滅率>99.9%;
- HEPA+活性炭雙重過(guò)濾:攔截顆粒雜質(zhì),吸附有害揮發(fā)物。
- 可設(shè)定定時(shí)自動(dòng)開(kāi)啟、循環(huán)滅菌;
- 可人機(jī)共存使用,無(wú)需關(guān)閉車間;
- 實(shí)時(shí)監(jiān)控運(yùn)行狀態(tài),異常報(bào)警提醒。
- 接種室、純種保存區(qū)
- 發(fā)酵車間、小試車間
- 發(fā)酵罐周邊工作區(qū)、包裝灌裝區(qū)
- 菌劑成品存放區(qū)
標(biāo)簽:
觀微生物
- 藥廠潔凈區(qū)消毒關(guān)鍵技術(shù):濕熱滅菌的應(yīng)用與要點(diǎn)
- 高壓蒸汽滅菌原理及實(shí)驗(yàn)室適合用高壓蒸汽滅菌的物品分享
- 臺(tái)式、立式、臥式高壓滅菌器的優(yōu)缺點(diǎn)及適用場(chǎng)景
- 以色列滕氏滅菌器使用操作方法全解析
- 從宏觀到微觀,6個(gè)“菌”術(shù)語(yǔ)的解釋與精準(zhǔn)識(shí)別
- 實(shí)驗(yàn)操作中玻璃器皿的清洗處理全攻略
- 機(jī)載表面消毒(ASD)優(yōu)化關(guān)鍵步驟循環(huán)開(kāi)發(fā)流程的介紹及相關(guān)問(wèn)題解答
- 電子本生燈和酒精燈在教學(xué)實(shí)驗(yàn)中的特點(diǎn)比較
- 尤德生物推出購(gòu)紅外電熱滅菌器送耗材大禮包促銷活動(dòng)
- 慧榮和攜生物安全防護(hù)設(shè)備參展2025生物安全學(xué)術(shù)大會(huì)
- 創(chuàng)坤攜光觸媒空氣消毒機(jī)亮相第十九屆細(xì)胞產(chǎn)業(yè)大會(huì)
- 上海創(chuàng)坤與蘇州佰仕朗戰(zhàn)略簽約共啟光觸媒消毒新藍(lán)海
- 圓滿落幕:致微儀器2025BCEIA 展會(huì)精彩回顧
- 致微儀器(E2457展臺(tái))與您相約 BCEIA 2025
- 慧榮和科技攜過(guò)氧化氫消毒機(jī)等亮相2025亞太潔凈展
- 慧榮和參加第九屆空氣生物學(xué)與生物凈化防護(hù)研討會(huì)
Copyright(C) 1998-2025 生物器材網(wǎng) 電話:021-64166852;13621656896 E-mail:info@bio-equip.com






